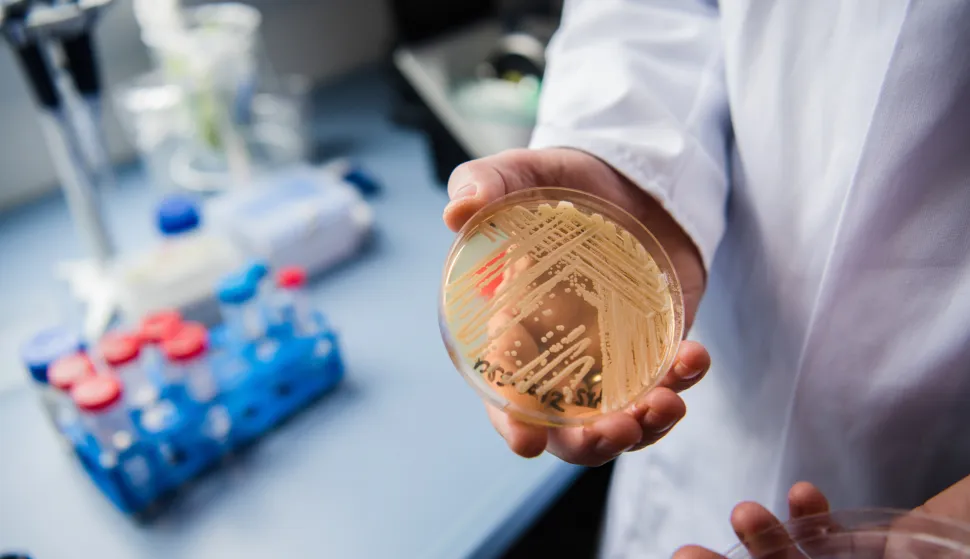
The director of the National Reference Centre for Invasive Fungus Infections, Oliver Kurzai, holding in his hands a petri dish holding the yeast candida auris in a laboratory of Wuerzburg University in Wuerzburg, Germany, 23 January 2018. There has been a recent rise of cases in Germany of seriously ill patients becoming infected with the dangerous yeast candida auris. Photo: Nicolas Armer/dpa /DPA/PIXSELL

Superinfekcija se širi Europom: Opasna gljivica otporna na lijekove stigla je i u naše bolnice
HZJZ potvrđuje da je hrvatski bolnički sustav dosad bio pošteđen, sve do ovog ljeta, kada se infekcija pojavila u Splitu
Superinfekcija gljivicom Candidom auris, otpornom na lijekove, stigla je i do Hrvatske. U kolovozu je u KBC-u Split zabilježen prvi slučaj zaraze u Hrvatskoj, u dva pacijenta, koja su i dalje hospitalizirana u toj bolnici. Riječ je o rezistentnoj gljivici koja se posljednjih godina širi europskim bolnicama i čini ozbiljnu prijetnju za pacijente i zdravstvene sustave, upozorio je ovih dana Europski centar za prevenciju i kontrolu bolesti (ECDC).
Prema podatcima Centra, u razdoblju od 2013. do 2023. godine, zemlje EU/EEA prijavile su više od 4000 slučajeva zaraze Candida auris, mahom u Španjolskoj, Grčkoj, Italiji, Francuskoj, Njemačkoj i Rumunjskoj. Samo u 2023. godini evidentirano je 1346 slučajeva u 18 zemalja.
Širi se po bolnicama
U Hrvatskom zavodu za javno zdravstvo (HZJZ) potvrđuju da je hrvatski bolnički sustav dosad bio pošteđen infekcije, sve do ovog ljeta, kada se pojavio u splitskom KBC-u. Candida auris uglavnom se širi u bolničkom sustavu, izazivajući ozbiljne infekcije u imunokompromitiranih bolesnika, a teško ju je kontrolirati jer se zadržava na površinama i medicinskoj opremi. U nekoliko zemalja zabilježen je i prijenos među pacijentima. Infekcija može dovesti do teških i potencijalno za život opasnih stanja, koja utječu na krvotok, dišni i središnji živčani sustav, unutarnje organe i kožu. Prosječno zdrave osobe ne bi trebale biti ugrožene.
U splitskoj bolnici potvrđuju da je ud dvije osobe potvrđena Candida auris, te su one i dalje na liječenju.
- Poduzete su adekvatne terapijske i epidemiološke mjere indicirane u slučajevima infekcija otpornim mikroorganizmima. Hospitalizacija osoba i dalje je u tijeku te se one liječe prema pravilima struke - poručuju iz Uprave KBC-a Split.
To je ujedno i jedini prijavljeni slučaj infekcije ovom gljivicom u Hrvatskoj. No u HZJZ-u očekuju da će se stanje i kod nas promijeniti idućih godina.
- Uvijek postoji potencijalna opasnost da postojeći patogen, koji je dokazan u svijetu i broj prijavljenih slučajeva raste svake godine, bude detektiran i u hrvatskim zdravstvenim ustanovama. Važno je da bolničko osoblje bude svjesno mogućnosti infekcije u rizičnoj skupini pacijenata i vodi računa o općim i specifičnim mjerama prevencije, suzbijanja i kontrole bolničkih infekcija - poručuju iz HZJZ-a.
Zbog čega se ova gljivica zapravo širi bolničkim sustavima diljem svijeta? Odgovor je jednak kao i za multirezistentne bakterije - prekomjerna upotreba antibiotika rezultira razvojem ovako otpornih mikroba.
Previše antibiotika
- Kandide su kvasci koji žive na našoj koži u malim količinama. Kad se pije puno antibiotika, onda se "potamane" bakterije po našem tijelu, tzv. mikrobiota, a kandide dobiju prostor jer na njih antibiotici ne djeluju. Do sada je to uglavnom bila Candida albicans, međutim, posljednjih nekoliko godina pojavila se Candida auris, kojoj je nezgodna osobina što je rezistentna na antifungike - objašnjava prof. dr. Arjana Tambić Andrašević, pročelnica Zavoda za kliničku mikrobiologiju Kinike za infektivne bolesti "Dr. Fran Mihaljević".
Poznato je da trošimo puno antibiotika, a rezistencija je samo posljedica takve prakse. Candida auris, kaže mikrobiologinja, ne mora biti smrtonosna. Ali ako “sjedne” na neki kateter, a pacijent dobije sepsu, važno je imati lijekove koji djeluju na uzročnika. Sve je više bakterija koje su rezistentne na lijekove, a pojava rezistentnih kvasaca liječnicima dodatno otežava borbu za izlječenje pacijenata.


